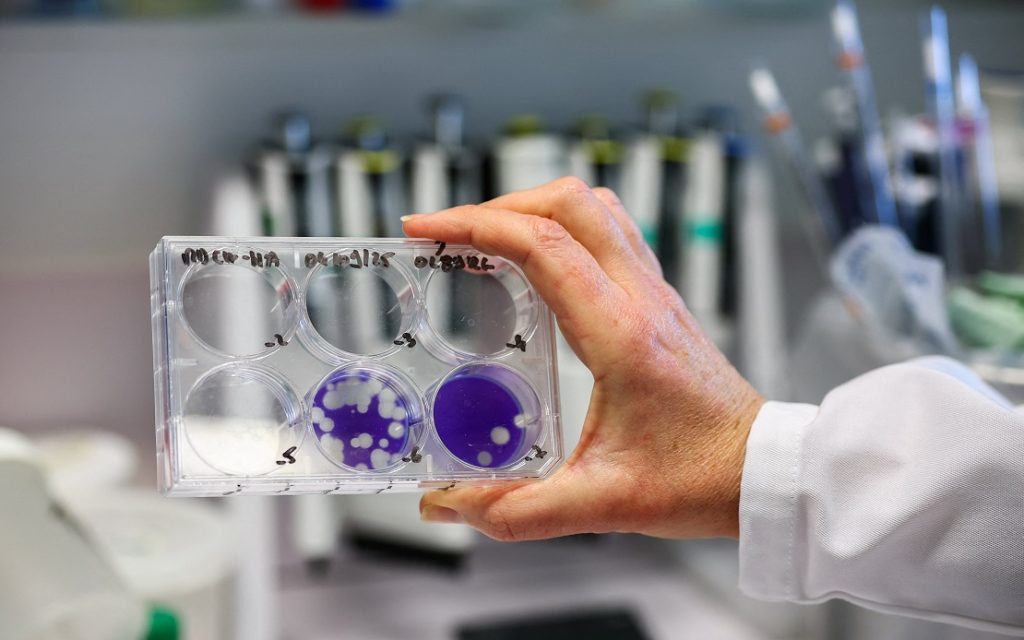

CIUDAD DE MÉXICO, 15 dic (NNN-ANDINA) — La Secretaría de Salud de México confirmó el viernes el primer caso detectado del virus de influenza A H3N2 subtipo K en la capital del país, aunque aseguró que no representa un “motivo de alarma” para la población, ya que el paciente ya se encuentra recuperado.
En un comunicado, la dependencia precisó que el caso fue confirmado por el Instituto Nacional de Enfermedades Respiratorias y que el paciente respondió favorablemente a un tratamiento ambulatorio con medicación antiviral.
La autoridad sanitaria destacó que esta variante, que ha circulado recientemente en Europa y Estados Unidos, “presenta características similares a las de la influenza estacional” y su manejo clínico es el mismo.
“La vacunación es la principal medida de prevención”, sostuvo la Secretaría, exhortando a la población a aplicarse las vacunas correspondientes a la temporada invernal, particularmente contra influenza, COVID-19 y neumococo, especialmente en grupos de riesgo como infantes y adultos mayores.
— NNN-ANDINA
